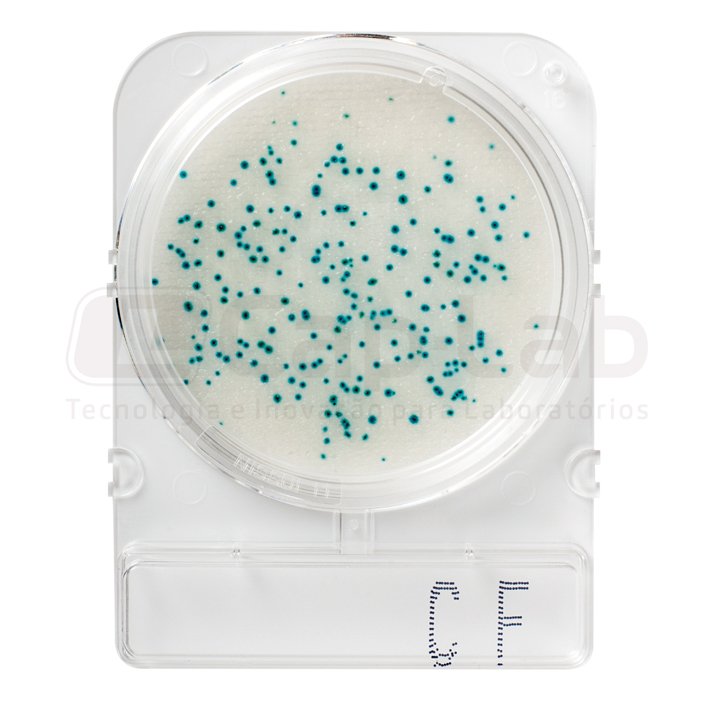

Compact Dry CF
Coliformes totais
Incubação: 18 – 24h
Temperatura: 37 ± 1°C
44°C (coliformes termotolerantes)
Descrição:
Compact Dry é um procedimento simples e seguro para determinar e quantificar microorganismos em produtos alimentícios, cosméticos e outras matérias-primas, incluindo produtos farmacêuticos. As placas cromogênicas Compact Dry prontas para uso são adequadas para os controles a serem realizados durante o processo e para os do produto final.
O Compact Dry CF é usado para a detecção rápida de coliformes: graças ao substrato cromogênico X-Gal, eles formam colônias características de azul / azul-verde. O crescimento de outros tipos de bactérias é bastante inibido. As bactérias que poderiam crescer apareceriam sem nenhuma coloração.
Especificações:
| Matriz: | Exposições de alimentos e superfícies |
| Tempo de incubação: | 24 horas |
| Temperatura de incubação: | 37 ° C |
| Embalagem: | 40 e 100 placas |
Modo de uso:
- Retirar a tampa.
- Coloque 1 ml da amostra no centro da superfície da placa Compact Dry.
- A amostra é automaticamente dispersa de forma homogênea e hidrata a camada de meio de cultura, transformando-o em gel em poucos segundos.
- Tampe a placa novamente e inicie a incubação.
Interpretação de resultados:
Os coliformes crescem para desenvolver colônias azuis / verdes, pois o meio contém o substrato da enzima cromogênica X-GAL. Outras bactérias além dos coliformes são inibidas para crescer e não formam colônias coloridas, mesmo que cresçam.
Armazenamento e prazo de validade:
- Manter em temperatura ambiente, de 1 a 30ºC.
- 18 meses de validade.